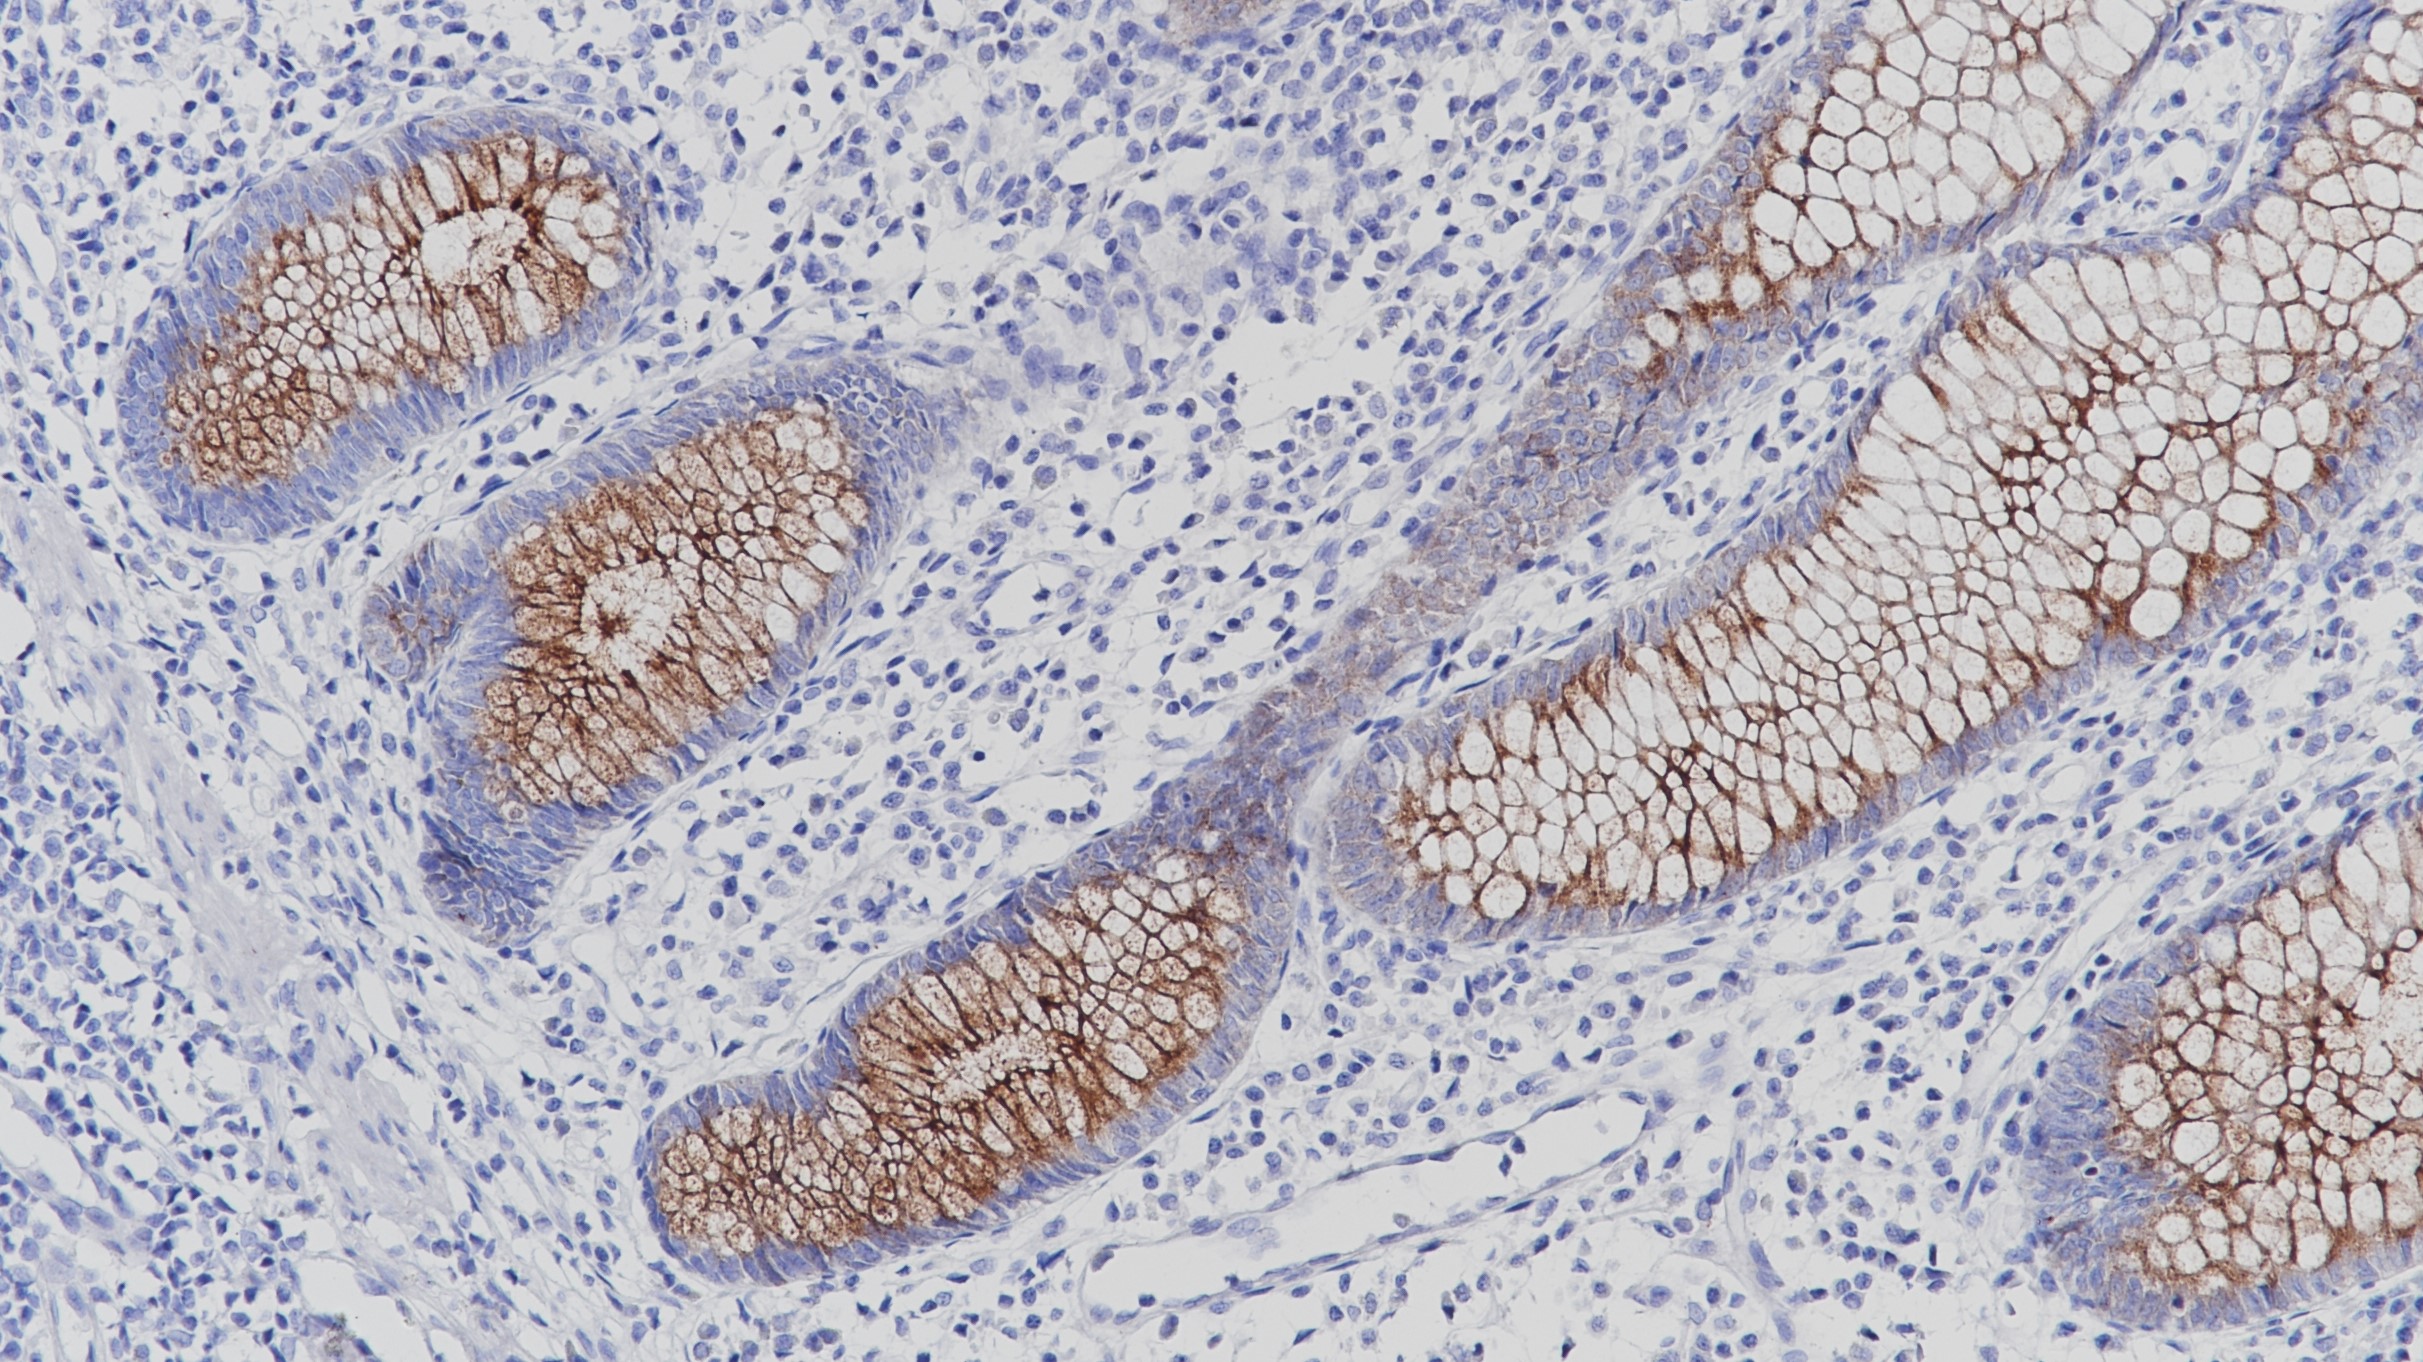
阑尾MUC4(BP6121)染色

1. Kaur S, Sharma N, Krishn S R, et al. MUC4-mediated regulation of acute phase protein lipocalin 2 through HER2/AKT/NF-κB signaling in pancreatic cancer.[J]. Clinical Cancer Research An Official Journal of the American Association for Cancer Research, 2014, 20(3):688-700.
2. Zhi X, Tao J, Xie K, et al. MUC4-induced nuclear translocation of β-catenin: a novel mechanism for growth, metastasis and angiogenesis in pancreatic cancer.[J]. Cancer Letters, 2014, 346(1):104-113.